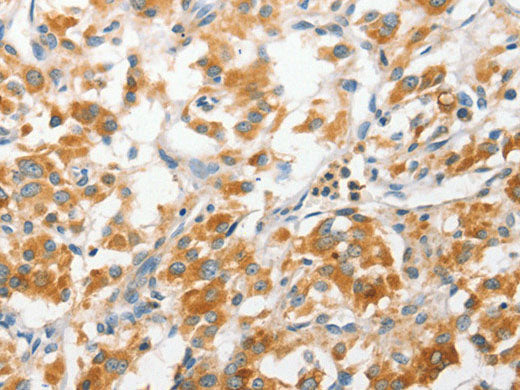
ANAPC2 Polyclonal Antibody Store at -20°C

ANAPC2 Polyclonal Antibody Store at -20°C
Couldn't load pickup availability

Still have questions? Ask our experts!
ANAPC2 Polyclonal Antibody Store at -20°C
| SKU # | E-AB-10808 |
| Reactivity | Human, Mouse |
| Host | Rabbit |
| Applications | IHC |
Product Details
| Isotype | IgG |
| Host | Rabbit |
| Reactivity | Human, Mouse |
| Applications | IHC |
| Clonality | Polyclonal |
| Immunogen | Recombinant protein of human ANAPC2 |
| Abbre | ANAPC2 |
| Synonyms | ANC2, APC2, Anaphase promoting complex subunit 2, Anaphase-promoting complex subunit 2, Cyclosome subunit 2, KIAA1406, OTTHUMP00000022692, RP11 350O14.5, anapc2 |
| Swissprot | |
| Cellular Localization | Cytosol, Nucleus, anaphase-promoting complex, nucleoplasm. |
| Concentration | 0.3 mg/mL |
| Buffer | Phosphate buffered solution, pH 7.4, containing 0.05% stabilizer and 50% glycerol. |
| Purification Method | Affinity purification |
| Research Areas | Cell Biology |
| Conjugation | Unconjugated |
| Storage | Store at -20°C Valid for 12 months. Avoid freeze / thaw cycles. |
| Shipping | The product is shipped with ice pack,upon receipt,store it immediately at the temperature recommended. |
Related Reagents
| Applications | Recommended Dilution |
| IHC | 1:50-1:200 |
Background
A large protein complex, termed the anaphase-promoting complex (APC), or the cyclosome, promotes metaphase-anaphase transition by ubiquitinating its specific substrates such as mitotic cyclins and anaphase inhibitor, which are subsequently degraded by the 26S proteasome. Biochemical studies have shown that the vertebrate APC contains eight subunits. The composition of the APC is highly conserved in organisms from yeast to humans. The product of this gene is a component of the complex and shares sequence similarity with a recently identified family of proteins called cullins, whicHuman, Mouseay also be involved in ubiquitin-mediated degradation.